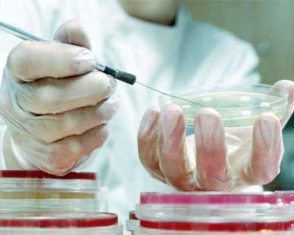

Луганская область испытывает нехватку вакцины против бешенства
- Войдите на сайт для отправки комментариев
- Подробнее
Обращение Северодонецкой организации общества Красного Креста
 Обращаемся к Вам, дорогие жители города, к руководителям государственных и частных предприятий, акционерных обществ и компаний, банковских и коммерческих структур, к коллективам профсоюзов принять участие в благотворительных акциях по предоставлению помощи нуждающимся, с просьбой оказать материальную помощь и поддержку подопечным Северодонецкой городской организации Общества Красного Креста для приобретения продуктов питания, средств первой необходимости, медицинских препаратов и помочь вместе с нами - нашим детям, лишенным родительского внимания, детям с ограниченными возможностями, прикованным к инвалидной коляске, ветеранам ВОВ, одиноким, больным людям преклонного возраста, тратящим большую часть денег на лекарства и услуги, отказывая себе в самом необходимом.
Обращаемся к Вам, дорогие жители города, к руководителям государственных и частных предприятий, акционерных обществ и компаний, банковских и коммерческих структур, к коллективам профсоюзов принять участие в благотворительных акциях по предоставлению помощи нуждающимся, с просьбой оказать материальную помощь и поддержку подопечным Северодонецкой городской организации Общества Красного Креста для приобретения продуктов питания, средств первой необходимости, медицинских препаратов и помочь вместе с нами - нашим детям, лишенным родительского внимания, детям с ограниченными возможностями, прикованным к инвалидной коляске, ветеранам ВОВ, одиноким, больным людям преклонного возраста, тратящим большую часть денег на лекарства и услуги, отказывая себе в самом необходимом.
- Войдите на сайт для отправки комментариев
- Подробнее
Просьба о помощи
 Добрый день! Обращаемся с просьбой о помощи на лечение ребенка Деревянко Даши, (дата рождения 25 сентября 2009 года).
Добрый день! Обращаемся с просьбой о помощи на лечение ребенка Деревянко Даши, (дата рождения 25 сентября 2009 года).
Состоялось заседание коллегии управления здравоохранения Северодонецкого горсовета
 На днях состоялось расширенное заседание коллегии управления здравоохранения Северодонецкого городского совета. В нем принял участие заместитель городского головы Сергей Федорович Терёшин.
На днях состоялось расширенное заседание коллегии управления здравоохранения Северодонецкого городского совета. В нем принял участие заместитель городского головы Сергей Федорович Терёшин.
- Войдите на сайт для отправки комментариев
- Подробнее
Правильно обращайтесь с продуктами летом - СЭС
 Лето – это и пора острых кишечных инфекций (ОКИ).В условиях повышенной температуры воздуха при попадании патогенных микроорганизмов в пищевые продукты, воду открытых водоемов, на предметы окружающей среды происходит их активное размножение и накопление, что в свою очередь ведет к возникновению заболевания.
Лето – это и пора острых кишечных инфекций (ОКИ).В условиях повышенной температуры воздуха при попадании патогенных микроорганизмов в пищевые продукты, воду открытых водоемов, на предметы окружающей среды происходит их активное размножение и накопление, что в свою очередь ведет к возникновению заболевания.
- Войдите на сайт для отправки комментариев
- Подробнее
СЭС предупреждает об энтеровирусной инфекции
В связи с обращением населения, средств массовой информации по вопросу повышенной заболеваемостью энтеровирусной инфекцией в Ростовской области, Северодонецкое горрайонное управление Госсанэпидслужбы в Луганской области напоминает о необходимости своевременного обращения за медицинской помощью в случае появления симптомов инфекционного заболевания (высокая температура тела, сильная головная боль, рвота, не приносящая облегчения) и соблюдения простых профилактических мер для предупреждения заражения.
В связи с обращением населения, средств массовой информации по вопросу повышенной заболеваемостью энтеровирусной инфекцией в Ростовской области, Северодонецкое горрайонное управление Госсанэпидслужбы в Луганской области напоминает о необходимости своевременного обращения за медицинской помощью в случае появления симптомов инфекционного заболевания (высокая температура тела, сильная головная боль, рвота, не приносящая облегчения) и соблюдения простых профилактических мер для предупреждения заражения.
- Войдите на сайт для отправки комментариев
- Подробнее
Будьте обережні при купанні у водоймах
Відділ цивільного захисту, екологічної безпеки та охорони праці міської ради звертається до мешканців та гостей міста.Станом на 9 липня 2013 року на водоймах Луганської області потонуло 43 людини, з них – 1 дитина. Головними причинами лиха є порушення правил безпечної поведінки під час купання або користування плавзасобами. Часто винуватцями надзвичайних подій є люди в нетверезому стані або діти, які залишившись без нагляду дорослих вигадують небезпечні розваги.
- Войдите на сайт для отправки комментариев
- Подробнее
Медична реформа торкнулася і лікувальних установ обласного центру, які надають меддопомогу дитячому населенню
Про результати та плани реалізації програми розвитку системи охорони здоров’я розповіли на брифінгу у Луганській міськраді. Для покращення якості лікування планується зосередити всі стаціонарні відділення в найбільшому лікувальному закладі - третій дитячій лікарні.
- Войдите на сайт для отправки комментариев
- Подробнее
В ближайшее время откроется Луганский областной перинатальный центр
11 июля 2013 года состоялось заседание общественного совета при облгосадминистрации. Впервые оно прошло в нестандартном формате: традиционный доклад был заменен посещением областного перинатального центра, где члены общественного совета обсудили перспективы защиты материнства и детства в Украине.
- Войдите на сайт для отправки комментариев
- Подробнее
Имеет место осложнение санитарной ситуации на водных объектах области
 Как показывает многолетний опыт с повышением температуры атмосферного воздуха и воды водных объектов, уменьшением их водности и увеличением рекреационной нагрузки ухудшается качество воды, а степень микробного загрязнения водоемов и водотоков в отдельных створах может достигать высокого и чрезвычайно высокого уровня, при несоблюдении требований санитарных правил может представлять реальную угрозу возникновения и распространения инфекционных заболеваний среди населения, в том и таких особо опасных как холера.
Как показывает многолетний опыт с повышением температуры атмосферного воздуха и воды водных объектов, уменьшением их водности и увеличением рекреационной нагрузки ухудшается качество воды, а степень микробного загрязнения водоемов и водотоков в отдельных створах может достигать высокого и чрезвычайно высокого уровня, при несоблюдении требований санитарных правил может представлять реальную угрозу возникновения и распространения инфекционных заболеваний среди населения, в том и таких особо опасных как холера.- Войдите на сайт для отправки комментариев
- Подробнее
- « первая
- ‹ предыдущая
- …
- 35
- 36
- 37
- 38
- 39
- 40
- 41
- 42
- 43
- …
- следующая ›
- последняя »

Последние комментарии
8 лет 40 недель назад
8 лет 40 недель назад
8 лет 40 недель назад
8 лет 41 неделя назад
8 лет 41 неделя назад
8 лет 41 неделя назад
8 лет 41 неделя назад
8 лет 42 недели назад
8 лет 42 недели назад
8 лет 42 недели назад